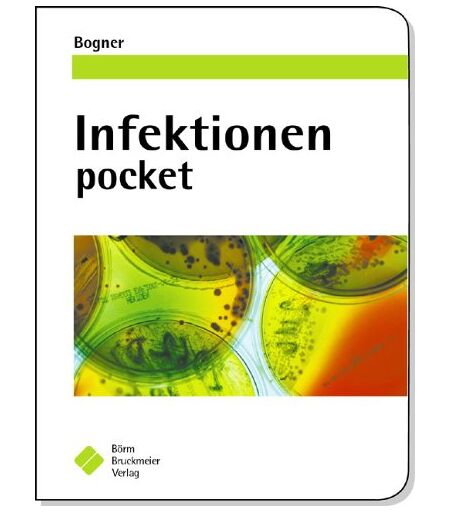

Johannes Bogner Infektionen Pocket
4,49 €
+ 1,99 €
Binding : Taschenbuch, Edition : 1., Aufl., Label : Börm Bruckmeier, Publisher : Börm Bruckmeier, medium : Taschenbuch, numberOfPages : 448, publicationDate : 2004-02-01, authors : Johannes Bogner, languages : german, ISBN : 3898622169 ...
Des produits similaires pourraient vous intéresser
Vendu par | Prix de l'article | Livraison | Prix total | |
---|---|---|---|---|
momox-shop.fr | 4,49 € | 1,99 € | 6,48 € |